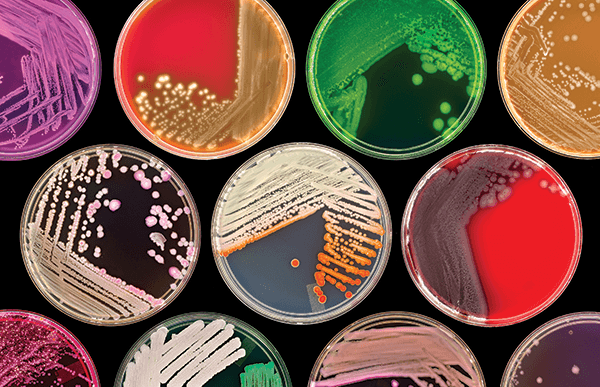

Culture medium is designed to support the growth of population of microorganisms or cells in vitro (outside the body ) via the process of cell proliferation.
The most common growth media are nutrient broths and agar plates .
The most common growth media are nutrient broths and agar plates .
Loading suggestions...